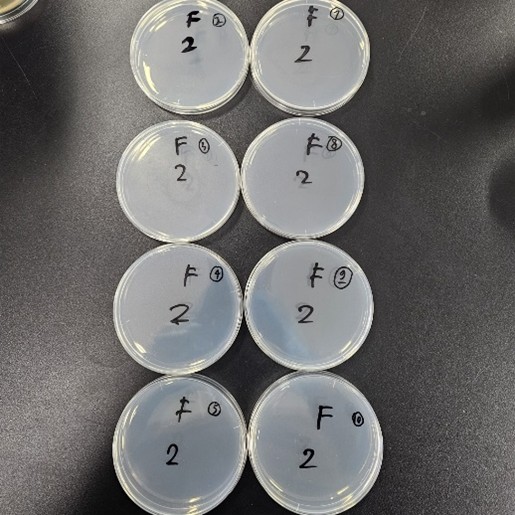

Penulis : Felix Dhanaputra Logianwy

Memastikan keamanan dari produk pangan bagi konsumen adalah suatu kewajiban penting bagi seorang ahli teknologi pangan. Ada beberapa metode yang bisa digunakan oleh ahli teknologi pangan untuk memastikan keamanan produk pangan, namun salah satu metode yang sering diandalkan adalah uji mikrobiologi. Pada dasarnya, dengan mengamati jumlah mikroorganisme (seperti bakteri dan jamur) tertentu yang tumbuh dari suatu produk pangan, ahli teknologi pangan dapat memastikan keamanan produk pangan.
Dari bulan Januari sampai Maret 2026, dua murid dari Universitas Ciputra Surabaya, Jurusan Food Technology Program (FTP), berkesempatan untuk menjalani program magang internasional di Jepang. Kedua murid ini, Aurelio dan Felix Dhanaputra Logianwy, belajar langsung dari para ahli teknologi pangan di perusahaan kopi Saza Coffee. Di perusahaan ini, mereka belajar mengenai pentingnya melakukan uji mikrobiologi dalam industri pangan.
Metode pengujian mikrobiologi di Jepang sedikit berbeda dari pengujian mikrobiologi yang biasanya dilakukan di Indonesia. Namun, prinsipnya tetaplah sama, yaitu mengamati jumlah mikroorganisme tertentu yang tumbuh dari bahan pangan yang diuji. Untuk menumbuhkan mikroorganisme, digunakan semacam agar-agar (disebut medium) yang diformulasikan untuk mendorong pertumbuhan bakteri tertentu, dan menghambat pertumbuhan mikroorganisme lain.
Medium pertumbuhan bakteri yang digunakan adalah :
- SMA (Standard Method Agar), digunakan untuk mengukur bakteri hidup secara umum (一般生菌/Ippanseikin). Mikroorganisme akan terlihat sebagai titik putih pada medium yang berwarna kuning terang. Fungsi media ini adalah memastikan jumlah mikroorganisme pada pangan, sehingga memudahkan untuk menilai mutu pangan.
- ECEAE (ES Colimark Agar ‘Eiken’), digunakan untuk mengamati bakteri koliform (大腸菌群/Daichōkin-gun) dan bakteri coli (大腸菌/Daichōkin). Bakteri koliform akan terlihat sebagai titik merah muda-keunguan, sedangkan bakteri E. coli akan terlihat sebagai titik biru-keunguan pada medium yang berwarna putih terang. Media ini penting untuk mengecek keberadaan kedua bakteri ini, yang dapat menyebabkan penyakit pencernaan seperti diare.
- MSA (Mannitol Salt Agar), digunakan untuk mengamati bakteri aureus (黄色ブドウ球菌/Kōshoku-budōkyūkin). Bakteri ini akan terlihat jelas sebagai titik kuning di medium yang berwarna merah. Media ini penting untuk mengecek keberadaan S. aureus karena bakteri ini dapat menyebabkan keracunan makanan.
- PDA (Potato Dextrose Agar), digunakan untuk mengamati jamur (真菌/Shinkin) yang umumnya terdapat pada peralatan produksi pangan. Jamur akan terlihat sebagai titik kelabu pada media yang berwarna putih bening. Tujuan penggunaan media ini adalah untuk mengecek keberadaan jamur, yang dapat menyebabkan keracunan makanan.
Menyadari bahaya yang dapat disebabkan oleh makhluk-makhluk tak kasat mata ini pada kesehatan kita, menekankan pentingnnya uji mikrobiologis terutama dalam bidang industri pangan. Kelalaian dalam tidak melaksanakan uji mikrobiologis memiliki konsekuensi yang berpotensi fatal. Maka dari itu, ahli teknologi pangan berusaha memahami dan mendalami dunia makhluk-makhluk tak kasat mata ini, untuk memastikan keamanan dari para konsumen produk pangan.





